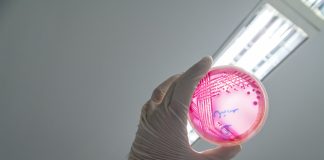

Schlagwort: Kinder
“Einzelkinder sind egoistischer” (und andere Klischees): Was ist dran an Geschwisterrollen?
STUTTGART. Im Kita-Alltag, im Klassenraum, in Elterngesprächen – Vorstellungen über Geschwisterrollen prägen oft den Blick auf Kinder. Einzelkinder gelten als egoistisch, mittlere Geschwister als...
Mehr Stress, mehr Druck, wenig Mitbestimmung: Warum sich die psychische Lage...
LEIPZIG. Die psychische Belastung von Kindern und Jugendlichen in Deutschland steigt erstmals seit Ende der Corona-Pandemie wieder an. Das aktuelle Deutsche Schulbarometer verweist auf...
Wie ein Mindestalter auf Social Media funktionieren könnte: Expertengruppe berät
BRÜSSEL. Social Media erst ab 14: Geht es nach SPD und CDU, sollten Kinder von Tiktok, Snapchat, Instagram und Co. fernbleiben. Könnte es dafür...
Kita-Sterben – wegen Kindermangels? “Es steht ein Wegbrechen der Strukturen bevor”
DRESDEN. Der demografische Wandel erreicht die Kitas mit Wucht – in Ostdeutschland jedenfalls. Sinkende Kinderzahlen führen zu weniger belegten Plätzen, ersten Schließungen und wachsender...
Immer mehr übergewichtige Kinder: Ärztepräsident schlägt Alarm – Brauchen wir ein...
BERLIN. Eine europaweite Vergleichsstudie gibt Deutschland in Sachen Gesundheitsprävention schlechte Noten. Der Präsident der Bundesärztekammer warnt angesichts von Bewegungsmangel und ungesunder Ernährung unter Kindern und...
COPSY-Studie: Krisen setzen Schülern massiv zu – die Folgen: Leistungsabfälle und...
HAMBURG. Krieg, Terror, wirtschaftliche Instabilität, Klimakrise – aber auch die Spaltung der Gesellschaft und die migrationspolitischen Debatten: All diese Themen lasten auf Schülerinnen und...
Erziehung: Wenn Eltern zu viel schützen und zu wenig führen –...
BERLIN. Eltern schützen ihre Kinder immer intensiver – und muten ihnen gleichzeitig immer weniger zu. Der Soziologe Norbert F. Schneider und die Psychotherapeutin Maria...
Podcast: „Kinder brauchen eine Lobby“ – ein Plädoyer für verbindliche Kita-Standards
BONN. Kitas sind weit mehr als Orte der Betreuung – doch in der politischen und öffentlichen Wahrnehmung spielt das kaum eine Rolle. Das kritisieren...
Wenn Kinder krank im Kopf werden – Forscher warnen: Psychische Probleme...
KÖLN. Die psychische Gesundheit von Kindern und Jugendlichen ist nicht nur eine Frage des individuellen Wohlbefindens – sie hat auch eine hohe wirtschaftliche Bedeutung....
Konfliktlösung ohne Gewalt – Prävention gegen Kriminalität beginnt in der Grundschule
OFFENBACH. Mäppchenklau im Klassenraum: Ein Theaterprojekt zeigt Kindern spielerisch, was man bei Konflikten tun kann. Die Stadt sieht dies als Teil ihrer Strategie zur...
Städte wollen Kinder aus Gaza aufnehmen – Bundesregierung stellt sich quer
HANNOVER. Städte sind mit dem Angebot, kranke und verletzte Kinder aus dem Gazastreifen und aus Israel aufzunehmen, an der ablehnenden Haltung der Bundesregierung gescheitert....
„Die Mehrheit der Kinder und Jugendlichen ist psychisch gesund“ – noch
BOCHUM. Klimakrise, Kriege, digitaler Dauerstress: Kinder und Jugendliche wachsen in einer Zeit voller Unsicherheiten auf. Psychische Gesundheitsfachkräfte sehen sie erstaunlich widerstandsfähig – doch die...
Einsamkeit von Schülern: Warum die Beziehung zu Lehrkräften so wichtig ist
HANNOVER. Knapp ein Viertel der Grundschulkinder fühlt sich einsam – „selbst mitten im Klassenzimmer“, wie ein Fachmann sagt. Eine Studie des Deutschen Jugendinstituts zeigt...
Ärzte rätseln: Madenwürmer und Läuse finden sich bei immer mehr Kindern
ERFURT. Mehr Kinder sind von Parasiten betroffen, in Thüringen jedenfalls (wie aktuelle Daten zeigen). Vor allem Madenwürmer breiten sich aus - während Krätzmilben zurückgehen....
Behörden alarmiert: Häufung von EHEC-Infektionen unter Kindern und Jugendlichen
SCHWERIN. Das vermehrte Auftreten von EHEC-Infektionen bei Kindern hat die Behörden in Mecklenburg-Vorpommern alarmiert. Mindestens vier werden aktuell auf Intensivstationen behandelt.
In Mecklenburg-Vorpommern gibt es eine...